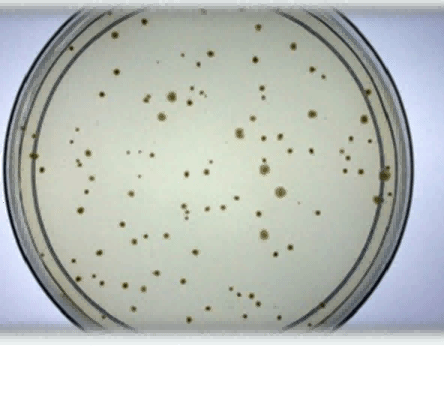

- 基本信息
- 品牌:Moltox
- 产地:美国
- 货号:26-532
- 用途范围:Ames实验
- 规格:100mL
- 是否进口:是
MOLTOX®的宗旨是为广大客户提供符合规范的标准产品、所有产品都是完全符合GLP规范的要求、所有产品都附带有质量控制报告。20多年来MOLTOX®一直致力于为广大的科研组织、质控部门以及药物研发机构提供高效高质量的相关试剂、菌株和代谢活化产品(S9)。同时提供及时的相关服务和技术支持,以期更好的服务于客户。
所提供的S9以及TA97a,TA98,TA100,TA102等产品已作为他的优势产品,在全球范围内被使用。所有菌株都来自于它的原始菌株或菌种保藏中心。例如:沙门氏菌来自于Dr. Bruce Ames实验室,加利福尼亚大学伯克利分校;大肠杆菌来自于英国NCIMB保藏中心。随产品提供应用与质量控制报告,详细列明了来源、生物学特性以及诊断性诱变剂测试结果。
Genetic Toxicology
遗传毒理试验能检测出DNA损伤以及损伤的固定。检测污染物的遗传毒理效应,以发现污染物对人体的潜在危害。MOLTOX®提供细菌突变实验所用到的一系列产品。MOLTOX齐源代理有代谢活化、培养基及试剂、阳性对照、鼠伤寒沙门氏菌株、诱变分析试剂盒、预制平板,肉汤及相关试剂、S9混合液配制相关试剂、表型确认培养基、顶层琼脂、 营养琼脂、营养肉汤及添加剂等分类产品
冻干S9-齐源生物现货供应
冻干S9-利用专利冻干技术,产品稳定,特别适用于无法提供超低温储存环境的,例如没有超低温冰箱,无法用干冰运输或者成本太高等等。用标注量的无菌纯化水复溶后即用。Moltox®所提供的致突变测试菌株大部分是方便使用的干燥颗粒形式。只有很少一部分不适用于冻干的菌株是以混悬液的形式保存在特制的转移培养基中。
冻干S9-齐源生物现货供应
多氯联苯(Aroclor 1254)诱导的雄性SD大鼠肝脏微粒体酶S9(0.15M 11-101.1 1 ml
货号:11-101 KCL) (为最常用的S9)根据Maron&Ames(Mutat res, 113:173, 11-101.2 2 ml
1983)使用50mg/kg剂量的多氯联苯诱导 11-101.5 5 ml
鼠伤寒沙门氏菌TA97突变型菌株冻干 TA97/TA97a
货号:71-097L
品牌:MOLTOX
产品系列:STDiscs™
包装:10颗/瓶
保存条件:2-8℃
有效期:2 年
产地:美国
鼠伤寒沙门氏菌 TA98突变型菌株冻干 TA98
货号:71-098L
品牌:MOLTOX
产品系列:STDiscs™
包装:10颗/瓶
保存条件:2-8℃
有效期:2 年
产地:美国
鼠伤寒沙门氏菌TA100突变型菌株货号:71-100L
品牌:MOLTOX
产品系列:STDiscs™
包装:10颗/瓶
保存条件:2-8℃
有效期:2 年
产地:美国
鼠伤寒沙门氏菌TA102突变型菌株冻干 TA102
货号:71-102L
品牌:MOLTOX
产品系列:STDiscs™
包装:10颗/瓶
保存条件:2-8℃
有效期:2 年
产地:美国
鼠伤寒沙门氏菌 TA1535突变型菌株冻干 TA1535
货号:71-1535L
品牌:MOLTOX
产品系列:STDiscs™
包装:10颗/瓶
保存条件:2-8℃
有效期:2 年
产地:美国
伤寒沙门氏菌 TA1537突变型菌株冻干 TA1537
货号:71-1537L
品牌:MOLTOX
产品系列:STDiscs™
包装:10颗/瓶
保存条件:2-8℃
有效期:2 年
产地:美国
鼠伤寒沙门氏菌 TA1538突变型菌株Lyophilized STDisc TA1538
货号:71-1538L
品牌:MOLTOX
产品系列:STDiscs™
包装:10颗/瓶
保存条件:2-8℃
有效期:2 年
产地:美国
Moltox公司提供系列组氨酸缺陷型鼠伤寒沙门氏菌的标准菌株,常用的有七种提供:TA97 TA98 TA100 TA102 TA1535 TA1537 TA1538。其标准菌株直接来源于Ames实验室,有证书提供。Moltox公司提供的菌株包装形式为10颗/瓶,2-8度保存。齐源生物现货供应!